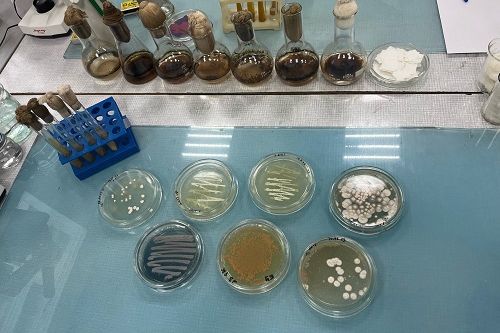
Профпроба "БИОРЕМЕДИАТОР"

22 декабря
Поздравляем стипендиатов!
Конец года стал для студентов Биолого-почвенного факультета ИГУ очень плодотворным. В конце декабря радостное известие: стипендия губернатора Иркутской области назначена сразу шести нашим студенткам. Чтобы получить такую стипендию необходимо проявить выдающиеся способности в учебной и научной деятельности.
Лауриатами стипендии губернатора, стали:
- Бирицкая Софья
- Имидоева Наташа
- Власова Анфиса
- Малыгина Екатерина
- Пеньдюхова Анна
- Тельнова Тамара
Поздравляем с победой!

19 декабря
Стипендия мэра
Студентам ИГУ вручены стипендии мэра в области науки и техники для нужд городского хозяйства. В этом году размер единовременной выплаты составил 25000 рублей.
Свидетельство вручил мэр Иркутска Руслан Болотов. В своих словах, он отметил важность поддержки молодых ученых и практическую значимость разработок для городского хозяйства Иркутска.
Поздравляем нашу студентку, Нелюбину Полину, которая стала лауреатом стипендии мэра!

5 мая
Выставка картин, посвященная 78-й годовщине Великой Победы.
4 мая в стенах факультета прошло открытие выставки картин, посвященная 78-й годовщине Великой Победы.
Выставка авторская, ученного-почвоведа, Венедикта Игнатьевича Бычкова (1922-2020), ветерана ВОВ, многие годы проработовавшего в стенах нашего факультета.
Выставка будет экспонироваться до 4 июня.
Приглашаем к посещению!

4 мая
Торжественное возложение цветов к мемориальной доске погибшим в годы войны студентам и преподавателям- биологам 4 мая 2023 года.
Сегодня в стенах факультета, прошло мероприятия приуроченое к 78 годовщине Победы в Великой Отечественной войне.
Студенты и сотрудники возлажили цветы к мемориальной доске и почтили память погибших солдат.